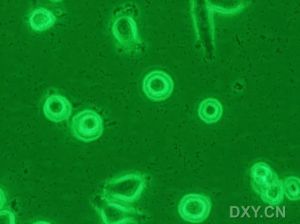
黑膠蟲

顯微鏡下的黑膠蟲
顯微鏡下的黑膠蟲概述
黑膠蟲到底是否為生物?這個一直是業內人士的疑惑。黑膠蟲一般是存在血清里的,而血清通常是經過0.1μm濾膜過濾的,所以血清里不可能存在細菌、黴菌及支原體等微生物。如果說黑膠蟲不是生物,它會不斷增多,達到一定數量時會與細胞競爭性生長,與細胞競爭培養基中的營養,從而使得細胞營養不足而死亡。
相關性
不管對於黑膠蟲的爭論如何,但有幾個是目前大家公認的:① 與細胞競爭性生長,對細胞生長有不利影響。② “黑膠蟲”會增殖,增殖多時,視野下一大片都為“黑膠蟲”。③ “黑膠蟲”與血清有關,與血清質量有很大關係。
“黑膠蟲”的定論
有2種解釋:
第一, 黑膠蟲為生物。它是小於細菌的生物,直徑小於0.1μm,大多國外血清中多見,可能是國外牛血清中含有的某種原蟲。只要它是生物,那么在培養基中一定會對細胞有影響。
第二, 黑膠蟲不是生物。國內的血清中,通常滅活之後都會有絮狀沉澱出現,而黑膠蟲出現時,所使用的血清被反覆凍融過多次。所以推測,所謂的“黑膠蟲”其實就是血清中的某些蛋白成分的物質,經過滅活之後喪失活性,在培養基中,鏡檢見到的運動其實是這些物質在溶液中做“布朗運動”。隨著細胞消耗培養基,這些物質越來越多,最後細胞所用的營養消耗完,細胞容易死亡。
處理方法
首先,血清買回來滅活前凍融應逐級凍融,即按照-20℃——4℃完全融化後,再置入水浴中,與室溫一起升高到56度,這樣的目的是避免溫度驟變,導致血清中的營養物質喪失活性。第二,血清滅活後分裝保存。按照每次用血清的量分裝,儘量減少血清凍融的次數。分裝時注意無菌。第三,細胞培養時血清濃度稍大一些。通常細胞培養血清濃度為10%-15%,但如果血清凍融次數過多,那營養物質喪失活性,按15%的濃度配製事實上達不到15%的營養成分,故培養基配置時一般用18%-20%的血清。
其他
這種黑膠蟲,在國外稱其為- 納米細菌,現將我看到的一些資料轉述如下,希望對大家有所幫助:
1.納米細菌的發現
芬蘭的一個科學家Ciftcioglu et al 在其細胞培養過程中, 發現在胎牛血清中存在一種直徑50-500 nm的微粒; 這種顆粒物對伽瑪射線具有很強的耐受性; 針對包括支原體在內的所有已知微生物的特異性檢測實驗均為陰性; 這種顆粒物在血瓊脂培養基以及支原體培養基中無法生長, 通常的細菌染色方法難以著色. 因此, Kajander判定這是一種新的微生物, 根據其體型微小並且棲息在血液中的特點, 將其命名為Nanobacterium sanguineum, 簡稱Nanobacteria, 中文譯名納米細菌, 並將菌種保存於德國微生物存儲中心 (DSM No: 5819-5821, the GermanCollection of Micro-organisms, Braunschweig, Germany).
2 納米細菌的生物學特性
2.1 納米細菌——哺乳動物體內最小的細菌 細胞培養時所使用的血清通常採用過濾法達到無菌的目的, 通常採用直徑0.1 μm的濾膜過濾除菌. Kajander研究發現, 0.1 μm的濾膜過濾並不能有效地清除血清中的納米細菌, 但是血清經過0.05 μm的濾膜過濾則能有效清除納米細菌污染. 細胞培養條件下的納米細菌經過0.2 μm的濾膜過濾後約有3%的納米細菌可以通過濾膜, 而在加壓過濾的情況下, 約有50%的納米細菌可以通過0.2 μm的濾膜. 剛剛經過過濾的納米細菌在相差顯微鏡下無法發現, 但在不含血清添加劑的細胞培養液中培養24 h後, 即可以用相差顯微鏡觀測到. 電子顯微鏡觀察顯示, 納米細菌的平均直徑為200 nm, 而子代納米細菌的最小直徑僅50 nm. 傳統的觀點認為, 只有當細胞直徑在不低於140 nm時, 才能維持其最基本的新陳代謝. Kajander認為, 納米細菌可能是地球形成早期、在原始大氣條件下的一種最原始的生命形式, 因此不能用衡量已經經過幾十億年進化的生命形式的觀點去衡量這種古老的生命形式, 並且推測, 納米細菌遭受不良因素的侵害後可以形成許多的體形微小的碎片, 並將其釋放到環境中, 每一個碎片都可能攜帶部分遺傳信息, 在特定條件下, 這些"基本"顆粒聚集在一起形成群落, 當足夠數量的"基本"顆粒提供完整的遺傳信息時, 則可以形成新的納米細菌.
2.2 納米細菌緩慢的增殖周期
微生物學家通常是通過對某種微生物進行培養, 進而了解該種微生物的特性. 然而, 並非每種微生物都是可以在實驗室中進行培養的,主要原因在於這些微生物的培養條件我們並不清楚, 其生存環境以及是否與其他微生物存在共生關係我們並不十分了解. 納米細菌就是一種對生長環境要求非常苛刻的微生物, 其新陳代謝率極為緩慢, 僅為普通細菌的1/10 000. 研究發現, 納米細菌主要利用環境中的胺基酸而不是葡萄糖來提供能量, 谷氨醯胺、天冬醯胺以及精氨酸均可被其利用. 在37 ℃有50-10 mL/L的二氧化碳及900-950 mL/L的空氣存在的潮濕環境下, 並且在含有100 mL/L胎牛血清和適量谷氨醯胺的pH值7.4的細胞培養基中, 納米細菌能夠緩慢生長, 平均倍增時間為3 d,而在無血清的細胞培養基中, 其增殖速度變慢, 細菌倍增時間可延長至5-6 d, 在添加適量促納米細菌生長因子BGF(一種桿菌培養上清的超濾液)或N3(納米細菌培養上清的超濾液)的條件下, 其增殖速度加快, 倍增時間可縮短至0.6-1 d. 在有促納米細菌生長因子BGF存在的條件下, 納米細菌甚至可以在固體培養基中生長, 並形成直徑l mm大小的細菌集落.
2.3 納米細菌獨特的生物礦化現象
 黑膠蟲
黑膠蟲2.4納米細菌的檢測方法 由於納米細菌在標準微生物培養基中無法生長, 並且即便是在最適宜其生長的細胞培養環境中, 納米細菌的生長也極為緩慢, 其新陳代謝率僅為普通細菌的萬分之一, 這使得許多基於檢測細菌新陳代謝的微生物學方法無法檢測納米細菌的存在. 由於納米細菌難以用傳統的火焰法和乙醇法固定, 並且大多數染料無法穿透其細胞壁, 而且不能用普通顯微鏡對其進行觀察, 因此常規的細菌學染色法並不能檢測到納米細菌的存在. 通過Kajander et al 的研究, 發現70℃乾烤10 min, 可以將其有效固定; 另外, 用茜素紅S、剛果紅以及硝酸銀染料可以使納米細菌著色; 而培養狀態下的納米細菌可以在放大400倍的相差顯微鏡下清晰地觀察其生長情況; 用DNA螢光染料 (DAPI或Hoechst) 按普通細菌DNA染色的條件對納米細菌DNA進行染色均不成功, 而當按照線粒體DNA以及病毒DNA染色條件, 對納米細菌DNA進行染色時, 螢光顯微鏡下可以觀察到特徵性的螢光; 用納米細菌特異性抗體進行螢光染色也可以清晰地顯示納米細菌的存在; 利用電子顯微鏡對經過負染的納米細菌進行觀察, 可以清晰的顯示80-350 nm大小、單獨或聚集成簇的納米細菌以及其表面的生物被膜(biofilm)結構; 而用透射電鏡對納米細菌的超薄切片進行觀察, 可以清晰的顯示其內部結構。

